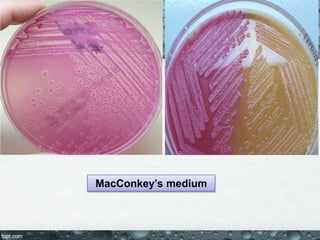
MacConkey’s medium
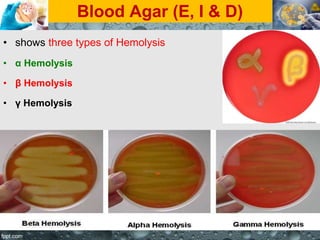
Blood Agar (E, I & D)
• shows three types of Hemolysis
• α Hemolysis
• β Hemolysis
• γ Hemolysis
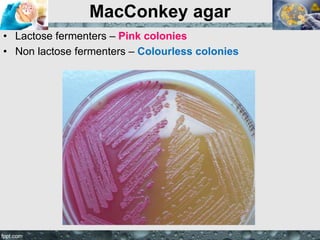
MacConkey agar
• Lactose fermenters – Pink colonies
• Non lactose fermenters – Colourless colonies
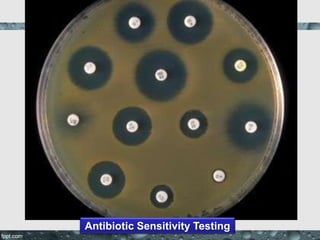
Antibiotic Sensitivity Testing

Culture media are used to grow microorganisms outside the body. They consist of water, energy sources, carbon sources, nitrogen sources, minerals, and sometimes special growth factors. Culture methods include solid, liquid, and semi-solid media. Common techniques are streak plating to isolate colonies and pour plating for viable counts. Special media like enriched, selective, differential and indicator media are used to isolate specific microbes or detect certain properties. Proper culture methods and conditions are needed to grow different microorganisms.